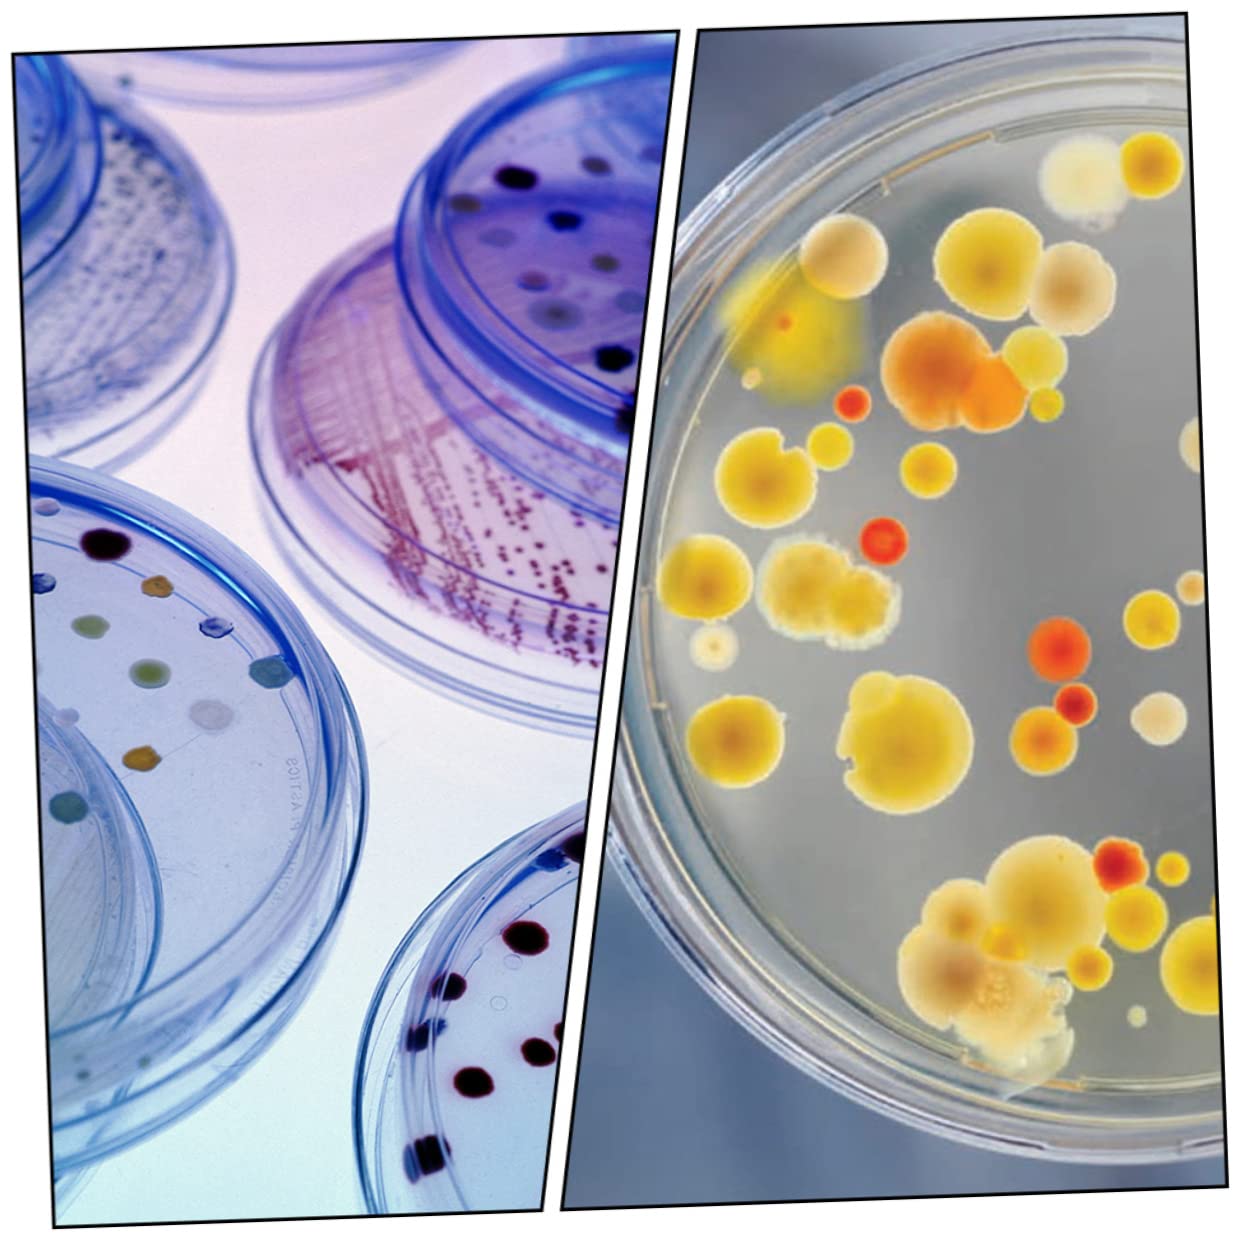
FUNOMOCYA 30pcs Vessel Laboratory Petri Dish Culture Petri Dishes Petri Dish for Culture Yeast Petri Dish with Lids Transparent Petri Dishes Petri Dish Plastic

Product Information
Specification
Brand : FUNOMOCYA
BulletPoint : sterile
BulletPoint1 : Petri dish:all items in this set are made of plastic, which are , reusable and ,petri dish with lids
BulletPoint2 : Petri dish for culture yeast:transparent window design for easy take and no longer get dusty laying out,laboratory petri dish
BulletPoint3 : Plastic petri dishes:every petri dish made of plastic material, which is a useful tool for you in science experiment,culture petri dish
BulletPoint4 : Transparent petri dishes:easy to observe and the bottom flat and smooth without distortion, which makes the quantitative analysis more accurate,plastic petri dish
BulletPoint5 : Culture petri dishes:professional and design with beautiful appearance, easy to carry and use, petri dish
Color : Transparent color
ItemDisplayDimensions_Length : 3.94 inches
ItemDisplayWeight : 0.67 pounds
ItemName : FUNOMOCYA 30pcs Vessel Laboratory Petri Dish Culture Petri Dishes Petri Dish for Culture Yeast Petri Dish with Lids Transparent Petri Dishes Petri Dish Plastic
ItemPackageDimensions_Height : 4.33 inches
ItemPackageDimensions_Length : 9.84 inches
ItemPackageDimensions_Width : 9.84 inches
ItemTypeKeyword : science-lab-petri-dishes
ItemVolume : 1 cubic_centimeters
Manufacturer : FUNOMOCYA
Material : Plastic
MeasurementAccuracy : 90 x 15 mm
ModelNumber : O31642NXC94Q67FI504EV4
NumberOfItems : 1
NumberOfLithiumMetalCells : 1
PartNumber : O31642NXC94Q67FI504EV4
ProductDescription : Package Include
10 x 35mm petri dishes 10 x 60mm petri dishes 10 x 100mm petri dishes
Characteristics
- Material: Plastic Petri Dish for Culture .
- Size: 1000X1000X150 cm/ 393X393X059 inch Plastic Petri Dish.
- Color: Transparent Laboratory Petri Dish.
- Not easily broken, the lid designed to be easy to cover and reduce pollution Culture Petri Dishes.
- Easy to observe and the bottom flat and smooth without distortion, which makes the quantitative analysis more accurate Culture Petri Dish.
- Transparent window design for easy take and no longer get dusty laying out Transparent Petri Dishes.
- Professional and design with beautiful appearance, easy to carry and use Petri Dish with Lids.
- Culture dishes is and uniform in thickness, but also light and thin Petri Dish.
Goods Description
Plastic Petri Dishes The special structure improves the strength lid and bottom of pot, improves flatness and increases adsorption of inner wall of culture dish.Petri Dish for Culture Petri dish laboratory dishes are widely used in schools, scientific laboratories, inoculation, scribing and separation, plant collection, observation, cultivation
ProductSiteLaunchDate : 2024-11-08T21:07:12.543Z
Size : M
SupplierDeclaredDgHzRegulation : not_applicable